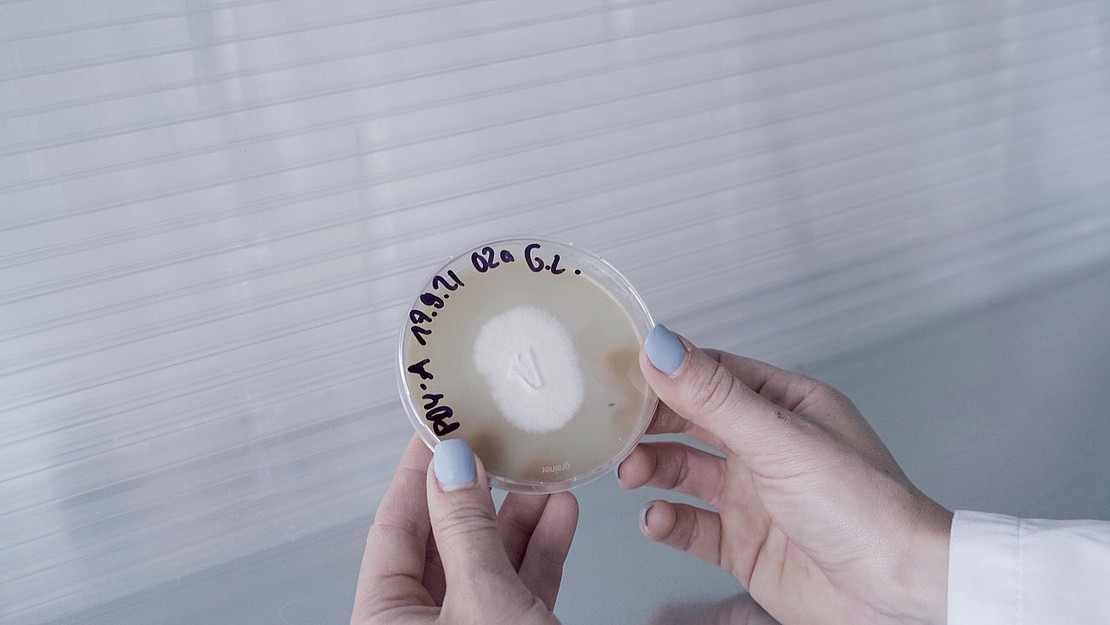

BIOLAB - Transdisziplinäre Arbeits- und Forschungsumgebung für gestalterische und künstlerische Auseinandersetzung mit biologischen Organismen
Worum geht es?
An der Schnittstelle zwischen Design und Biologie ist das BIOLAB eine Arbeits- und Forschungsumgebung, die Studierenden der Kunsthochschule Kassel und der Universität Kassel die Möglichkeit bietet, sich gestalterisch, künstlerisch und wissenschaftlich mit lebenden Organismen auseinanderzusetzen. Gemeinsam mit Partner*innen aus dem wachsenden Netzwerk bietet es transdisziplinäre Lehr-Lernveranstaltungen, transformative Forschung sowie eine Plattform zum fachlichen Austausch an.
Steckbrief
Fachgebiet
Nachhaltige Produktgestaltung (Prof. Dr. Ritzmann)
Ökologie (Prof. Dr. Langer)
Experimentelles und Digitales Entwerfen und Konstruieren (Prof. Eversmann)
Laufzeit
seit September 2023
Projektwebseite
These/weitere Detailinformationen
Das BIOLAB ist ein Raum in dem gestalterischen Forschen stattfindet. Die Arbeitsumgebung an der Kunsthochschule inklusive eines Netzwerks aus DesignerInnen, ArchitektInnen, BiologInnen und KünstlerInnen steht auch Studierenden zur Verfügung. Damit ist ein Experimentierraum eingerichtet, in dem neue Arbeitstechniken und Möglichkeiten mit biologischen Stoffen – Pilzen, Algen, Bakterien – erlernt werden können.
Im Wintersemester 23/24 findet eine transdisziplinäre Lehrveranstaltung statt, die sich darauf konzentriert, die zukunftsweisende Potenziale myzelbasierter Entwicklungen zu beleuchten. Diese basieren nicht nur auf nachwachsenden, biologisch abbaubaren Rohstoffen, sondern provozieren auch neue Prozesse im Rahmen von Herstellung und Wachstum.
Je Semester wird im Rahmen des BIOLAB ein kompaktes transdisziplinäres Lehr-Lern-Angebot für Studierende der beteiligten FB stattfinden. So können Anwendungshorizonte und aktuelle Forschungsfragen, die praktische Auseinandersetzung und Fragestellungen der Nachhaltigkeit von biologischen Materialien vermittelt und erforscht werden.
Fördermittelgeber
Gefördert durch:
Universität Kassel - ZFF und ZLF